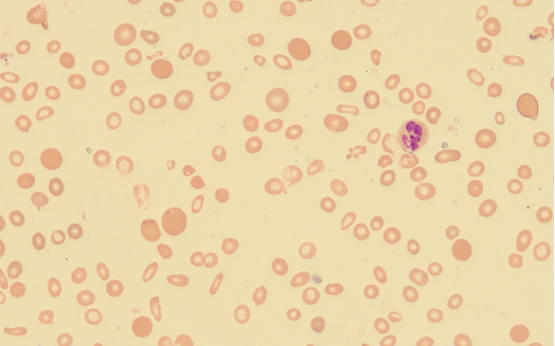
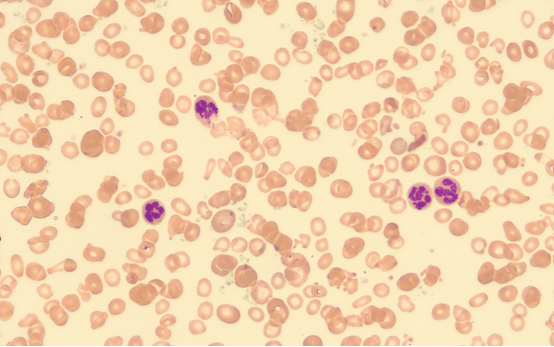

检验案例 | 贫血类型及病因,看检验科是怎么分析的!
更新时间:2020/8/28 14:19:45 浏览次数:6021病例简史:
老年女性,83岁,于20天前无明显诱因下出现四肢乏力、面色苍白,活动后有气促,无头晕、头痛,无发热、畏寒,无心悸、胸闷,无腹痛、腹胀,未予重视;4天前患者诉症状加重,伴有心悸、胸闷,纳差、排黑便1次,无腹痛、腹胀,无排血便、恶心、呕吐,经休息后症状无缓解。既往行胃毕II式切除术,伴关节肿痛多年。
体检:
T 36.6℃,P 126次/分,R 20次/分,BP 149/55mmHg。神志清晰,贫血貌,呼吸平稳,问答切题,口齿清晰,查体合作。双眼睑结膜苍白,全身皮肤粘膜无黄染,无瘀点瘀斑,无出血点,全身浅表淋巴结无肿大,颈软,无抵抗,颈静脉无充盈,气管居中,胸部外形正常,叩诊双肺呈清音,双侧呼吸运动对称。双肺呼吸音清,双肺未闻及湿啰音、干啰音,HR:126次/分,律齐,杂音未闻及,腹部平坦,无压痛,无反跳痛,肝脾肋下未及,双下肢无浮肿,病理征阴性。
辅助检查:
血常规:白细胞 8.69 *109/L ,红细胞 2.01 *1012/L ↓,血红蛋白 32.0 g/l ↓,血小板 186.0 *109/L ,红细胞压积 0.124 ↓,平均血红蛋白量MCH 15.9 pg ↓,平均血红蛋白浓度 258.0 g/l ↓,平均红细胞体积MCV 61.7 fl ↓。网织红细胞绝对值0.028 *1012/L ↓,网织红细胞千分比10.9‰ 。
尿常规:无异常。
便常规:潜血弱阳性。
Coombs试验(直接、间接):均阴性。
生化:血清铁2.8umol/l ↓,总铁结合力63.5umol/l,不饱和铁结合力60.7umol/l↑,铁饱和度0.04↓,转铁蛋白2.9g/l,总蛋白52.5g/l↓,白蛋白33.8g/l,球蛋白18.7g/l,总胆红素25.8umol/l↑,直接胆红素9.6umol/l↑,间接胆红素16.2ummol/l,总胆汁酸19.6umol/l↑,余未见明显异常。
免疫:类风湿因子65.9IU/ml↑,抗核抗体(阳性),着丝点蛋白B(阳性)。
贫血三项:铁蛋白5.00ug/l↓,维生素B12为1117.5pmol/l↑,叶酸23.83ug/l。
腹部彩超:未见明显异常。
胃镜:1、残胃炎;2、毕II式术后改变。
肠镜:1.盲肠息肉 2.直肠息肉 3.痔。
病例分析:
通过外周血常规检查分析,患者处于重度贫血状态,根据红细胞相关参数可归类至小细胞低色素性贫血大类。这类贫血中临床上常见的有缺铁性贫血、珠蛋白生成障碍性贫血、铁粒幼细胞性贫血等。分析生化结果及铁蛋白,考虑患者缺铁性贫血可能性大。铁蛋白、血清铁、铁饱和度降低,总铁结合力、不饱和铁结合力、转铁蛋白正常或升高反映出机体缺铁的状态,也可基本排除铁粒幼细胞性贫血。铁粒幼细胞性贫血是指机体本身不缺铁、而幼红细胞利用铁障碍导致小细胞低色素性贫血,此种病理状态下血清铁、铁饱和度、铁蛋白等一般不降低。针对于贫血的病因分析,最常规也非常有实用意义的实验室检查就是外周血形态分析。通过外周血涂片(图1、2)我们可以发现,成熟红细胞大小不一,异形明显,可见中央淡染区扩大、面包圈样红细胞,未见珠蛋白生成障碍性贫血相关的靶形等异常形态。但是同时我们还可以发现,巨大成熟红细胞(非体积偏大的嗜多色网织红细胞)、分叶过多(分叶大于6叶)的中性粒细胞多见。该形态异常易见于巨幼细胞性贫血患者血象。但是该患者叶酸含量正常,且维生素B12较高以至于超出检测线性范围。于是矛盾就发生了,怎么回事呢?是什么原因导致的外周血粒细胞分叶过多及出现巨红细胞呢?
图1
图2
为进一步确诊贫血的病因,建议临床进行骨髓穿刺涂片检查。虽然,结合外周血常规、生化检查、铁蛋白、外周血形态分析、患者胃切除病史及胃肠镜检查、便潜血阳性检查结果能得出缺铁性贫血的诊断。但是外周血其他的形态异常不能单以缺铁来解释。为排除恶性血液病及地中海贫血等其他病因,临床拟进行骨髓穿刺行流式、地贫基因、涂片形态分析。骨髓涂片形态如图3、4、5、6,可见有核细胞增生活跃,G=24.50%、E=66.00%、G/E=0.4:1;粒系比例相对减低,可见巨幼变杆状核及晚幼粒细胞,易见多分叶中性粒细胞;红系比例明显增高,以中晚红为主,可见巨幼变、花瓣核、含豪焦小体幼红细胞,成熟红细胞大小不一,异形明显,可见中央淡染区扩大、面包圈样红细胞、巨大红细胞。涂片铁染色(图7、8)检查可见,图7外铁(阴性),图8内铁(阳性率0%)。流式细胞学检查未见异常。地贫基因突变检查未见异常。

图3

图4

图5

图6

图7

图8
从骨髓涂片结果来分析,可以发现缺铁病因得到进一步确证,同时也验证了可能合并巨幼细胞性贫血的外周血形态分析初步结论。那么,一个矛盾点是B12及叶酸均正常。患者是否入院前接受过补充治疗?检验医师的的作用此刻就可以发挥了,详细了解患者现状及既往病史、治疗用药史,及时与主管医师进行交流与沟通,共同研究患者病因、病情变化及转归。通过与主管医师探讨病情、交换意见,同时共同查房、详细补充临床病史及用药信息发现,患者由于行胃毕II式切除术后经常伴有肢体麻木的异样感觉,于是寻求便民诊所帮助,长期服用甲钴胺(维生素12为有效成分)缓解症状,因此进行入院检测时B12血液含量不低反而升高。考虑到患者肢体麻木可能由于胃切除术后B12吸收欠佳导致含量缺乏而引起神经系统症状。同时,患者由于多年关节肿痛考虑诊断类风湿性关节炎,于便民诊所长期服用甲氨蝶呤等拮抗叶酸的药物。汇总这些信息可以得出结论,患者由于胃切除术后饮食及吸收受影响,同时残胃炎、肠道息肉、痔等致慢性消化道失血丢铁导致缺铁性贫血;胃切除术后由于胃体壁细胞减少,内因子的分泌量随之减少可导致B12吸收欠佳,血清B12含量降低诱发贫血或肢体麻木等神经系统症状;患者长期口服甲钴胺可干扰入院血清B12的检测结果;患者关节肿痛,类风湿因子及多项自身抗体阳性提示不排除类风湿关节炎等自身免疫性疾病,患者长期服用低剂量甲氨蝶呤可拮抗叶酸的生理作用,导致血细胞巨幼变及粒细胞过分叶状态。因此患者可能并存缺铁性贫血及药物导致的巨幼细胞性贫血。由于缺铁性贫血影响了MCV的计算结果,导致血常规数据提示巨幼细胞性贫血的可能性被掩盖,同时由于患者自身伴随疾病及治疗用药的影响,针对于巨幼贫的B12、叶酸检测也未能给出提示性意义。此时,直观的血细胞形态分析显得尤为重要了。本例中,检验医师结合细胞形态及详细的病史用药史提示诊断极易忽略的巨幼细胞性贫血状态,可帮助主管医生多方面权衡,进行更全面的治疗。
因此,在完善病史及用药信息、结合各项实验室检查后,检验医师协助临床得出缺铁性贫血合并巨幼细胞性贫血的诊断,建议患者在针对贫血治疗的同时,咨询风湿免疫科进行科学、规范的抗类风湿关节炎的治疗,以避免缺铁性贫血纠正后使得巨幼细胞性贫血的矛盾凸显出来。
扫描下载体外诊断头条APP
扫描关注CAIVD官方微信
扫描关注CAIVD官方视频号
扫描关注CACLP官方微信
扫描关注CACLP官方视频号
全国卫生产业企业管理协会实验医学分会
( 京ICP备15010734号-10 )



